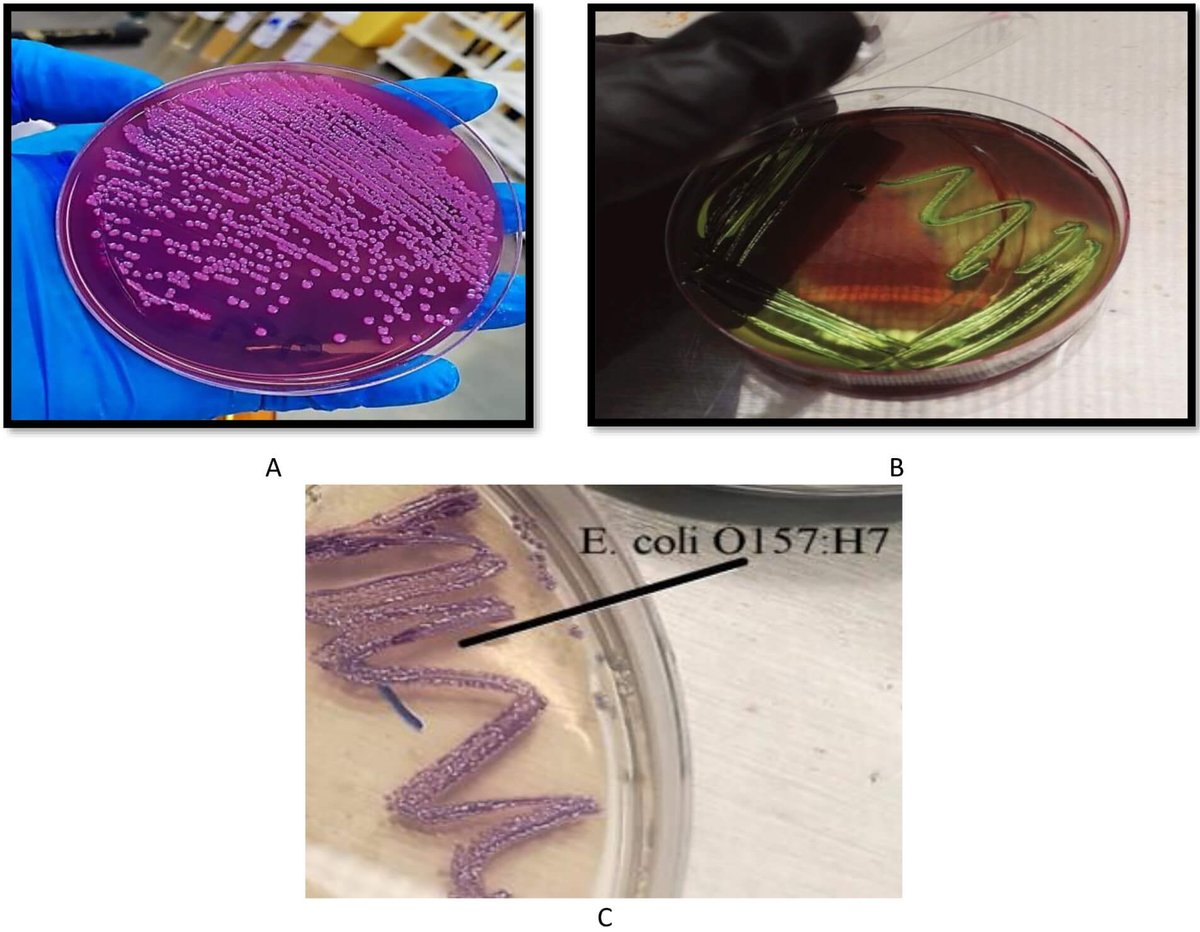
Tweet media

The latest work from Pusan National University @PusanUni by Prof. Dae Hyun Kim and from Kyungsung University by Asst. Prof. Min Hi Park and their team is now featured in FBL!
Welcome to read this article 👉: https://t.co/ISUVLH2wLr
Article Highlights
💡 How do everyday https://t.co/CDU69YkCjH
Welcome to read this article 👉: https://t.co/ISUVLH2wLr
Article Highlights
💡 How do everyday https://t.co/CDU69YkCjH


0
0
9
1.3K
0
Circadian control of DNA repair may shape cancer outcomes
Find More Research: https://t.co/VnXx8SHkmA
New research reveals that homologous recombination is not constant across the day. In human cells, DNA end resection follows a circadian rhythm, peaking in the early morning. https://t.co/VT8zYaKdKQ
Find More Research: https://t.co/VnXx8SHkmA
New research reveals that homologous recombination is not constant across the day. In human cells, DNA end resection follows a circadian rhythm, peaking in the early morning. https://t.co/VT8zYaKdKQ



0
3
9
5.0K
5
Immune cells in the lung may be holding a key clue to long COVID. 🫁🧬
https://t.co/SqTUQAIEF0
We turned a new finding into a quick quiz — can you spot how lung macrophages mirror circulating monocytes in severe respiratory long COVID?
Dive into the full blog to unpack what this https://t.co/KSFbYnhyYs
https://t.co/SqTUQAIEF0
We turned a new finding into a quick quiz — can you spot how lung macrophages mirror circulating monocytes in severe respiratory long COVID?
Dive into the full blog to unpack what this https://t.co/KSFbYnhyYs

0
3
6
3.8K
0
A Distinct Monocyte State Links Immune Dysregulation to Lung Damage in Long COVID
Find More Research: https://t.co/VnXx8SHkmA
Long COVID is increasingly understood as a systemic immune disorder rather than a purely post-viral condition. A new study identifies a distinct https://t.co/k8BcFoAghi
Find More Research: https://t.co/VnXx8SHkmA
Long COVID is increasingly understood as a systemic immune disorder rather than a purely post-viral condition. A new study identifies a distinct https://t.co/k8BcFoAghi



0
3
6
4.8K
0
Microsystem Technologies Accelerating Immunotherapy Discovery and Translation
https://t.co/JWlP472j75
Introduction
Immunotherapies, such as CAR‑T cells and checkpoint inhibitors, are reshaping cancer and autoimmune disease treatment but remain hindered by variable efficacy, https://t.co/Df3KSZttiD
https://t.co/JWlP472j75
Introduction
Immunotherapies, such as CAR‑T cells and checkpoint inhibitors, are reshaping cancer and autoimmune disease treatment but remain hindered by variable efficacy, https://t.co/Df3KSZttiD

0
3
6
916
1
Rhinovirus doesn’t change. Your airway does.
https://t.co/hmEHwNQ7X8
Rhinovirus causes a mild cold for most people.
But in asthmatics and smokers, it can spiral into real respiratory distress.
Why?
New research shows the difference isn’t the virus — it’s the signaling logic of https://t.co/TrJ5mvj0AB
https://t.co/hmEHwNQ7X8
Rhinovirus causes a mild cold for most people.
But in asthmatics and smokers, it can spiral into real respiratory distress.
Why?
New research shows the difference isn’t the virus — it’s the signaling logic of https://t.co/TrJ5mvj0AB

1
3
6
902
0
🧬⏳ From Bench to Future|Can We Rewind Aging by Rewriting Gene Control?
https://t.co/4LbtXArXdc
Systematic identification of transcription factors driving cellular rejuvenation
What if aging isn’t just damage accumulation—but a mis-set gene regulatory program? This study https://t.co/NzCq3pbYeH
https://t.co/4LbtXArXdc
Systematic identification of transcription factors driving cellular rejuvenation
What if aging isn’t just damage accumulation—but a mis-set gene regulatory program? This study https://t.co/NzCq3pbYeH

0
3
9
2.7K
1
🧬 How meiosis genes shape recombination & aneuploidy
Find More Research: https://t.co/5R0v3vifKZ
Meiosis ensures accurate chromosome segregation and genetic diversity, but errors can cause aneuploidy, a leading contributor to pregnancy loss and congenital disorders.
Key https://t.co/W5PFtEeHhY
Find More Research: https://t.co/5R0v3vifKZ
Meiosis ensures accurate chromosome segregation and genetic diversity, but errors can cause aneuploidy, a leading contributor to pregnancy loss and congenital disorders.
Key https://t.co/W5PFtEeHhY

0
3
7
1.6K
1
🧪 Quick quiz for cancer immunology folks:
Read the full story 👇
https://t.co/LN722Lx4by
How can a gut microbial metabolite rewire bone-marrow myelopoiesis and make metastasis less likely?
Our latest blog dives into how chemotherapy-induced dysbiosis → IPA → macrophage-biased https://t.co/2xINTEeJAg
Read the full story 👇
https://t.co/LN722Lx4by
How can a gut microbial metabolite rewire bone-marrow myelopoiesis and make metastasis less likely?
Our latest blog dives into how chemotherapy-induced dysbiosis → IPA → macrophage-biased https://t.co/2xINTEeJAg

0
3
8
5.2K
1
🧫 New cancer–microbiome insight
Find More Research: https://t.co/VnXx8SHkmA
Chemotherapy doesn’t just kill tumor cells — it rewires the immune system via the gut.
Here’s what the research shows 👇
• Chemotherapy induces intestinal dysbiosis
• Tryptophan-metabolizing bacteria https://t.co/F4SyZmo8r1
Find More Research: https://t.co/VnXx8SHkmA
Chemotherapy doesn’t just kill tumor cells — it rewires the immune system via the gut.
Here’s what the research shows 👇
• Chemotherapy induces intestinal dysbiosis
• Tryptophan-metabolizing bacteria https://t.co/F4SyZmo8r1



0
3
6
6.3K
0
Not all fat is bad — losing beige fat may actively raise blood pressure. 🫀🔥
https://t.co/rnByZ0A0dv
New evidence shows that ablation of PRDM16, a key regulator of beige adipocyte identity, triggers vascular remodeling and hypertension.
Key insights 👇
• Beige fat normally https://t.co/4cTMpEhUmF
https://t.co/rnByZ0A0dv
New evidence shows that ablation of PRDM16, a key regulator of beige adipocyte identity, triggers vascular remodeling and hypertension.
Key insights 👇
• Beige fat normally https://t.co/4cTMpEhUmF

0
3
6
1.9K
1
The latest work from Alfaisal University @Alfaisaluniv by Prof. Khalid S. Mohammad and Dr. Fatimah Bu Izran is now featured in FBL!
Welcome to read this article 👉: https://t.co/FYDACCwc59
Article Highlights
💡 Could TGF-β be the master conductor of the vicious cycle driving https://t.co/k8rBFzVUka
Welcome to read this article 👉: https://t.co/FYDACCwc59
Article Highlights
💡 Could TGF-β be the master conductor of the vicious cycle driving https://t.co/k8rBFzVUka



0
0
6
224
0
The latest work from Al-Nahrain University by Prof. Rebah N. Algafari and his team is now featured in FBE!
Full article👉: https://t.co/PB2npfCKt4
💡How do specific gene mutations influence antibiotic resistance in E. coli O157:H7?
#EcoliO157H7 #AntibioticResistance #ShigaToxin https://t.co/CmkP8tPzqj
Full article👉: https://t.co/PB2npfCKt4
💡How do specific gene mutations influence antibiotic resistance in E. coli O157:H7?
#EcoliO157H7 #AntibioticResistance #ShigaToxin https://t.co/CmkP8tPzqj

0
0
6
210
0
What immune cell type was once considered too difficult to generate through transcriptional reprogramming alone — until combinatorial TF screening changed the game?
https://t.co/d9dJSFpGee
🧠 We break down how platforms like REPROcode uncover hidden transcriptional “recipes” for https://t.co/TMRwyhxvhh
https://t.co/d9dJSFpGee
🧠 We break down how platforms like REPROcode uncover hidden transcriptional “recipes” for https://t.co/TMRwyhxvhh

0
3
6
1.6K
0
A Combinatorial Transcription Factor Screening Platform for Immune Cell Reprogramming
Find More Research: https://t.co/VnXx8SHkmA
Immune cell identity and function are tightly governed by transcription factor (TF) networks. However, identifying which combinations of TFs can https://t.co/p1B8ELKQxp
Find More Research: https://t.co/VnXx8SHkmA
Immune cell identity and function are tightly governed by transcription factor (TF) networks. However, identifying which combinations of TFs can https://t.co/p1B8ELKQxp



0
4
7
2.6K
0
What if treating gliomas isn’t just about shrinking the tumor—but targeting where it starts?
🔍 Read, think, and research smarter.
https://t.co/B0b0u7EdKC
Recent research shows IDH-mutant gliomas arise from glial progenitor cells, revealing new metabolic and immunological https://t.co/wKRhtTt4jX
🔍 Read, think, and research smarter.
https://t.co/B0b0u7EdKC
Recent research shows IDH-mutant gliomas arise from glial progenitor cells, revealing new metabolic and immunological https://t.co/wKRhtTt4jX

0
3
7
1.8K
0
IDH-Mutant Gliomas Originate from Glial Progenitor Cells Harboring the Initial Driver Mutation
Find More Research: https://t.co/VnXx8SHkmA
Understanding the origins of glioma is critical for interpreting tumor behavior and therapeutic response. Growing evidence indicates that https://t.co/8HomTowEA4
Find More Research: https://t.co/VnXx8SHkmA
Understanding the origins of glioma is critical for interpreting tumor behavior and therapeutic response. Growing evidence indicates that https://t.co/8HomTowEA4



0
4
8
6.8K
0
The latest work from Saint Camillus International University of Health Sciences and Sapienza University of Rome @SapienzaRoma by Assoc. Prof. Federica Campolo and her team is now featured in FBL!
Welcome to read this article 👉: https://t.co/EubUeMArzp
Article Highlights
💡 https://t.co/2VNY2w3OL6
Welcome to read this article 👉: https://t.co/EubUeMArzp
Article Highlights
💡 https://t.co/2VNY2w3OL6

0
1
9
1.9K
0
7.4K
Total Members
+ 0
24h Growth
+ 1
7d Growth
Date Members Change
May 26, 2026 7.4K +0
May 25, 2026 7.4K +0
May 24, 2026 7.4K +1
May 23, 2026 7.4K +0
May 22, 2026 7.4K +0
May 21, 2026 7.4K +0
May 20, 2026 7.4K +0
May 19, 2026 7.4K +0
May 18, 2026 7.4K +1
May 17, 2026 7.4K +0
May 16, 2026 7.4K +0
May 15, 2026 7.4K -1
May 14, 2026 7.4K -2
May 13, 2026 7.4K —
No reviews yet
Be the first to share your experience!
Share Your Experience
Sign in with X to leave a review and help others discover great communities
Login with XLoading...
Join us to nerd out about Cell Biology! Non-model and model organisms both welcome!
Community Rules
Be kind and respectful.
Keep Tweets on topic.
Explore and share.





